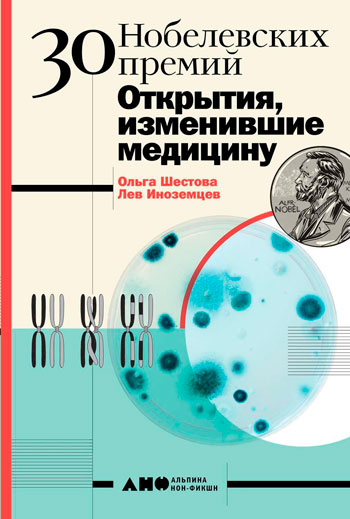

«Полка новинок»





















«Полка новинок»
Выпуск 65
 |
В шестьдесят пятом выпуске представлена научно-популярная литература по таким отраслям знаний как астрофизика и психология, медицина, а также издания для досуга. И, как всегда, художественные произведения на все вкусы: фантастика, детективы, исторические приключения, современная проза и мемуары. Напоминаем, для пользователей, зарегистрированных на сайте, доступно для просмотра содержание издания. Если вас заинтересовало все издание целиком или конкретная глава, можете воспользоваться услугами библиотеки – электронной доставкой документов (подробнее: http://lib-dpr.ru/index.php?text=edd) и межбиблиотечным абонементом (подробнее: http://lib-dpr.ru/index.php?text=mba). |

Фрейлина: моя невероятная жизнь в тени Королевы

Вечное чудо жизни

Доктор Пес

Семь лет в Тибете: Моя жизнь при дворе Далай-ламы

Лучший из лучших

Лихорадка

Ревность и другие истории

Песнь призрачного леса

Колода предзнаменований

Пожирающая серость

Сердце, которое помнит

Владимир Высоцкий и Марина Влади. Бард и француженка

Моя тайная жизнь

Дочь королевы сирен

Милочка Мэгги

Свой, чужой, родной

Военный госпиталь
30 Нобелевских премий: Открытия, изменившие медицину

Типы интуиции


